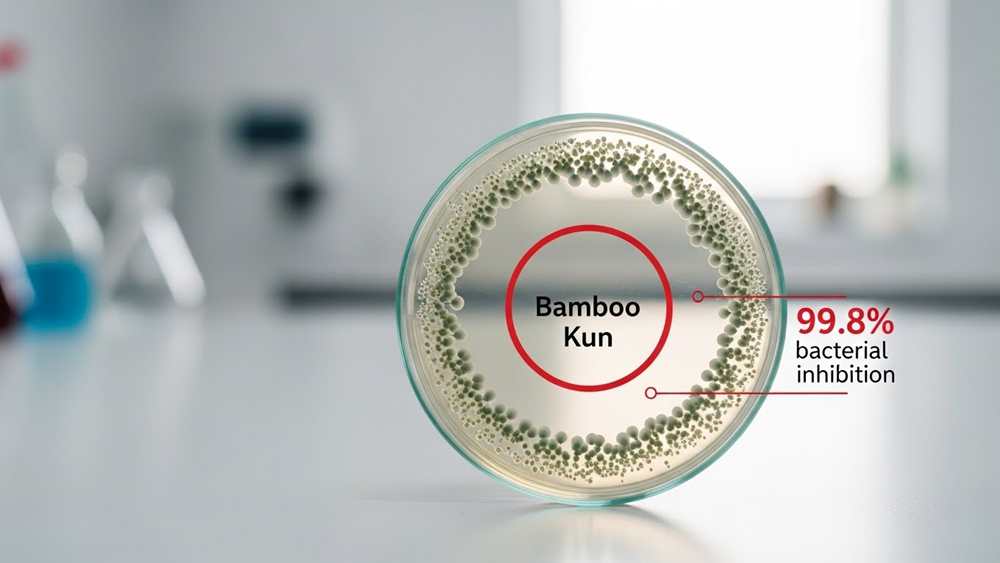

Industrial material procurement often forces a choice between environmental compliance and mechanical load-bearing capacity. Bamboo fiber engineering eliminates this compromise, delivering a tensile strength of 28,000 psi—nearly double that of high-grade oak—and a 99.8% bacterial inhibition rate through the integrated Bamboo Kun bio-agent. With a 10.7% CAGR and a projected 2030 valuation of $5.2 billion, the shift toward bamboo is driven by these empirical structural metrics rather than aesthetic trends.
This analysis examines the cellular geometry and 82.04 m²/g internal surface area that drive bamboo’s performance in high-stress B2B applications. We evaluate the technical viability of closed-loop NMMO extraction systems and assess how varieties like Kyushu-Moso meet Oeko-Tex Standard 100 and FSC sustainability benchmarks to ensure long-term operational profitability.
Bamboo Fiber Morphology: Why is it Naturally Stronger Than Wood?
Bamboo’s 28,000 psi tensile strength comes from rectangular cell geometry and multilayered walls, which pack more densely than wood to prevent structural failure under high stress.
| Performance Metric | Bamboo Fiber | Wood (Spruce/Hardwood) |
|---|---|---|
| Tensile Strength | Up to 28,000 psi | ~10,000–15,000 psi (Oak/Maple) |
| Tensile Modulus | ~28 GPa | ~25 GPa (Spruce) |
| Material Density | 1050–1200 kg/m³ | ~400–900 kg/m³ (Standard Woods) |
| Ultimate Stress | ~985 MPa | ~918 MPa (Spruce) |
The Cellular Architecture: Multilayered Walls and Tissue Density
Bamboo achieves superior stiffness through amplified cell wall formation. While spruce latewood relies on thinner structures, bamboo packs its fiber bundles with dense, multilayered walls that handle extreme loads without buckling.
Cell geometry gives bamboo a mechanical edge. Wood tracheids are typically rounded, but bamboo cells are rectangular. This shape allows cells to sit flush against each other, creating a tighter tissue matrix with fewer weak gaps.
Heavily lignified middle lamellae act as a high-strength biological adhesive. This bonding prevents cell-cell debonding. In hardwoods, this debonding is the primary cause of tissue failure under stress, but bamboo fibers remain locked together until much higher strain levels.
Comparative Performance Metrics: Tensile Strength and Moisture Stability
The raw data confirms bamboo’s industrial utility. Tensile strength reaches 28,000 psi, which leaves traditional oak and maple in the dust. This makes it a primary candidate for high-stress B2B applications, from construction reinforcements to premium paper pulp.
- Tensile Modulus: ~28 GPa (Outperforms high-grade spruce).
- Density Range: 1050–1200 kg/m³ (Exceeds many tropical hardwoods).
- Moisture Content: 6% to 9% (Maintains stability and fire resistance).
- Fiber Ultimate Stress: ~985 MPa.
Moisture management is a built-in feature. Bamboo maintains a low moisture content of 6% to 9%, significantly lower than most woods. This prevents the warping and rot common in traditional lumber and reduces the risk of combustion in industrial environments.
In pulp production, bamboo’s morphology offers a rare combination. It provides the fiber length of softwoods for strength, but the coarseness and softness of hardwoods for hygiene products. Manufacturers get bulk and water absorbency without the usual trade-offs.
“Bamboo Kun”: Is This the Ultimate Natural Anti-Bacterial Bio-agent?
Bamboo Kun is a lignin-based bio-agent providing 99.8% bacterial inhibition. It retains 70% efficacy after 50 industrial washes and meets Oeko-Tex Standard 100 safety requirements.
| Performance Metric | Technical Data |
|---|---|
| Bacterial Inhibition Rate | Up to 99.8% |
| Industrial Durability | 70% efficacy after 50 washes |
| Safety Certification | Oeko-Tex Standard 100 |
| Molecular Signature | FTIR Peak 1045 cm⁻¹ |
The Biochemical Mechanism: Lignin-Derived Protection
Bamboo Kun is not a topical chemical treatment. It is a natural bio-agent composed of phenolic and C-O/C-H functional groups that bind directly to cellulose molecules during plant growth. This integration creates a permanent biological defense system within the fiber structure.
- Target Pathogens: Specifically disrupts the cell walls of E. coli and S. aureus.
- Molecular Identification: FTIR spectroscopy confirms the role of lignin via the 1045 cm⁻¹ peak.
- Pesticide Elimination: Inherent antimicrobial properties remove the need for synthetic pesticides during cultivation.
The agent functions by physically disrupting bacterial membranes. Because this is a plant-based mechanism rather than a leachable toxin, the antimicrobial effect remains stable throughout the fiber’s lifecycle, provided the processing avoids harsh chemical degradation.
Efficacy Data: Bacterial Inhibition and Industrial Durability
Performance data shows that Bamboo Kun achieves near-complete CFU (Colony Forming Unit) reduction within 24 to 48 hours. Testing by the Fabrics Verification Association of Japan validates that these properties survive rigorous industrial cleaning protocols.
- 99.8% Inhibition: Natural bacterial suppression rate in raw and minimally processed bamboo.
- 50-Wash Durability: 70% of bacteria-destroying properties persist after 50 industrial cycles.
- Variant Performance: Heat-treated Kyushu-Moso bamboo powder shows superior resistance against S. aureus.
While viscose conversion can diminish the efficacy of Bamboo Kun, Oeko-Tex Standard 100 compliance ensures that the finished textile contains no harmful chemical residues. For hygiene-critical applications, choosing non-extraction methods or specific Japanese varieties like Kyushu-Moso provides the most reliable antimicrobial results.

The Porosity Secret: Why Does Bamboo Outperform Wood in Liquid Retention?
Bamboo captures liquid through a massive internal surface area of 82.04 m²/g. Its 33.8 nm micro-pores trigger stronger capillary effects than the coarser 445 nm pores found in wood.
Surface Area vs. Bulk Volume: The Micro-Cylinder Advantage
Bamboo prioritizes surface contact over raw cavity space. While pine has higher total porosity, bamboo’s internal structure functions as a dense network of micro-cylinders. This configuration creates a bottleneck effect that enhances moisture retention and surface-level adsorption despite a lower bulk pore volume.
- Specific Pore Area: 82.04 m²/g (Moso Bamboo) vs. 18.16 m²/g (Pinus sylvestris).
- Total Porosity: 47.58% in bamboo compared to 67.16% in pine.
- Structural Density: Approximately 680 kg/m³, supporting a rigid capillary system.
Technical Metrics: Pore Diameters and Capillary Adsorption Data
The engineering advantage lies in the pore diameter. Smaller pores increase capillary pressure, which drives bamboo’s superior liquid performance. High silica content in the outer stem layers interacts with this porous core to regulate moisture transport and maintain structural durability under liquid load.
- Median Pore Diameter: 33.8 nm in bamboo vs. 445.0 nm in pine.
- Engineered Porosity: Laminated bamboo composites can achieve levels as low as 9.8%.
- Fiber Cavity Diameter: 9.1 nm in refined bamboo structures.
- Silica Content: 0.5% to 4.0%, concentrated in the outer stem layers.
These metrics confirm that bamboo does not rely on volume to manage liquids. It relies on geometry. The vast internal surface area allows for rapid adsorption, while the narrow pore diameters ensure the liquid remains trapped via capillary action, outclassing the larger, less efficient cavities of traditional softwoods.
Scale Your Brand with Professional OEM Toilet Paper Manufacturing

Sustainability ROI: Can Quick Growth Cycles Offset Higher Processing Costs?
Bamboo’s 3-5 year maturity cycle and 33% net profit margins offset the high initial capital required for closed-loop NMMO extraction systems.
Standard processing costs for eco-friendly fibers often deter investment. However, bamboo’s biological growth rate changes the math. Rapid regeneration cycles create a volume-based hedge against the capital-intensive nature of closed-loop chemical extraction.
Yield Economics: Amortizing High Extraction Costs via Rapid Biomass Regeneration
Bamboo reaches maturity in 3 to 5 years, allowing for continuous annual harvesting without the need for replanting. This high-frequency yield increases land-use efficiency compared to traditional timber or cotton crops.
- Maturity Cycle: 3–5 years for full growth versus decades for hardwoods.
- Input Ratio: 1.43 tons of bamboo dust required per 1 ton of fiber.
- Tensile Strength: Up to 28,000 psi, ensuring high-value industrial output.
- Density: 1050–1200 kg/m³, which exceeds many tropical hardwoods.
CAPEX and Operational Benchmarks for Scaling Market Profitability
Profitability depends on industrial scale and solvent recovery efficiency. Plants processing over 2,000 tons annually achieve significant margins by recycling chemicals and minimizing waste in closed-loop systems.
- Gross Margins: Industrial plants report 49%–52%.
- Net Profit: 26%–33% after accounting for specialized pulping machinery.
- Chemical Efficiency: Consumption of 0.07 tons of NMMO per ton of fiber.
- Market Outlook: 10.7% CAGR with a 2030 valuation target of $5.2 billion.
Efficiency gains in NMMO-based systems lower long-term operating expenses. These systems satisfy OEKO-TEX and GOTS standards, securing the premium pricing necessary to pay back the initial machinery investment and achieve a positive Net Present Value.
The Softening Challenge: How to Achieve Silkiness Without Harsh Chemicals?
Bamboo achieves silkiness through mechanical enzyme refinement or closed-loop Lyocell processing, avoiding harsh softeners while maintaining OEKO-TEX safety standards and fiber integrity.
Mechanical and Enzymatic Softening: Physics-Based Fiber Refinement
Mechanical processing relies on physical force rather than synthetic chemical baths. Manufacturers crush bamboo stalks and apply natural enzymes to break down the cellular structure into a viscous pulp. This method preserves the fiber’s natural breathability and structural durability.
- Fiber Selection: Using long-strand fibers from mature bamboo stalks prevents loose ends, creating inherent surface silkiness.
- Refinement: Physical combing and spinning yield a chemical-free yarn with high air permeability.
- Maintenance: Gentle washing cycles and air-drying allow the fiber to soften naturally over time without synthetic lubricants.
Eco-Friendly Chemical Alternatives: Lyocell and Low-Alkali Pathways
For high-volume production requiring a silk-like hand-feel, closed-loop chemical systems have replaced traditional viscose methods. These pathways focus on non-toxic solvents and low-concentration solutions that protect the bamboo’s mechanical properties.
- Bamboo Lyocell (NMMO): Uses N-Methylmorpholine N-oxide, a non-toxic solvent, in a system where nearly 100% of the liquid is recycled.
- Low-Alkali Treatment: A 5% NaOH solution (pH=13) at 26°C for 2 hours reduces water absorption while maintaining the fiber’s Young’s modulus.
- Vegetable Oil Conditioning: Preheating fibers at 180°C followed by sunflower oil immersion at 26°C enhances moisture resistance without toxic runoff.
- XSBR Emulsion: 48% solid content (pH=8) immersion cycles stabilize fiber properties during 50-minute treatments.
- Compliance: Strict OEKO-TEX certification ensures zero residual carbon disulfide, common in standard viscose, remains in the final product.
These technical treatments allow bamboo to retain a tensile strength of up to 28,000 psi while achieving the softness of premium cotton. By prioritizing physics-based softening and closed-loop chemistry, brands meet sustainability targets without sacrificing the tactile quality consumers demand.
Final Thoughts
High upfront costs for closed-loop NMMO processing are the only barrier to market dominance. Bamboo’s 3-year maturity cycle delivers a volume-based ROI that traditional timber cannot match.
Shift procurement to FSC-certified, Lyocell-processed bamboo to capture premium hygiene and construction markets. Audit your supply chain for “Bamboo Kun” retention to justify 50% gross margins.
Frequently Asked Questions
Is bamboo toilet paper really anti-bacterial?
Bamboo fiber contains guaiacyl lignin, which features phenolic compounds and carboxylic acids that inhibit bacterial growth. Tests show bamboo achieves peak antibacterial efficacy against S. aureus within a 48-hour period.
Why is bamboo pulp stronger than hardwood pulp for tissue manufacturing?
Bamboo fibers average 1.55 mm in length, nearly double the 0.88 mm found in eucalyptus hardwood. This higher length-to-width ratio improves tensile strength and wet durability without the trade-offs typical of shorter fibers.
How does bamboo fiber feel compared to recycled paper?
Bamboo fiber is smoother and has better drapeability than recycled paper. While recycled pulp is often stiff and coarse, bamboo maintains a dry tensile strength of 2.33 cN/dtex while providing a “soft touch” feel.
Is bamboo toilet paper safe for all septic systems?
Safety depends on the product’s disintegration rate. To avoid disrupting the 3-5 year septic waste cycle, use high-quality bamboo paper free of additives that prevent it from breaking down within seconds of water contact.
What certifications prove bamboo is sustainably sourced?
FSC (Forest Stewardship Council) certification is the gold standard. It audits suppliers against 10 principles and 70 criteria to ensure responsible forest management, sustainable harvest rates, and protection of sensitive ecosystems.
How much water is saved in bamboo tissue production?
Bamboo production reduces water usage by 75%. It requires approximately 5,000 gallons of water per ton of pulp, whereas traditional wood pulp manufacturing consumes 20,000 gallons per ton.